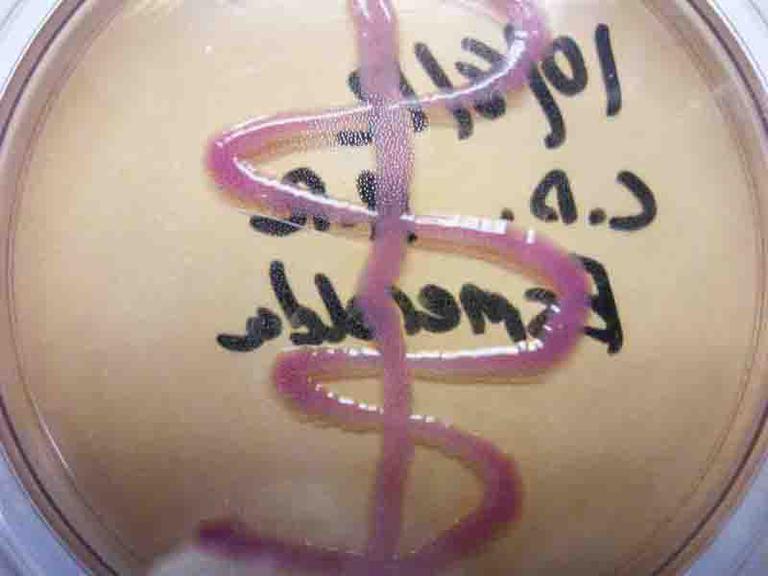

| ||||
MacConkey's Agar Images: Copyright FREE - P2
MacConkey's Agar showing lactose positive pink colony above a lactose negative colorless colony.
MacConkey's Agar growing a pink smiley face of E. coli.
Page last updated 8/2015
MacConkeys (back) & TSY agar (front) growing environmental sample from kitchen sink.
Unknown bacteria plated on Mannitol Salt Agar (left) and MacConkey's (right). Note that there is no growth on MacConkey's. So what do you think the unknown bacterium is?
SPO VIRTUAL CLASSROOMS
VIDEO: MacConkey's Agar Quiz and Review - How to Interpret MAC
The Microbiology Image Library is the largest photo collection on the SPO site. To help you more easily find what you're looking for, select the "See more" link of the sub-topic below that corresponds to your interests or use the search boxes.
The SPO Science Image Library is a continuously growing collection of copyright-free science photographs. If you use one of our free, low-res images, we just ask that you give us credit and provide a link to the SPO website (scienceprofonline.com). Click on photo to enlarge. To save a photo to your computer, right click on it and select "Save".
MacConkey's Agar growing E. coli, Enterobacter & Salmonella
(clockwise from top left plate).
MacConkey's Agar control plate growing E. coli (hot pink #5), & Salmonella (colorless #4). Staph epi and Staph aureus were also plated, but did not grow because Gram+.
MacConkey's Agar growing E. coli. Note pink color of bacteria due to lactose fermentation.
MacConkey's Agar growing Enterobacter. Note uneven pink color characteristic of a weak lactose fermenter.
MacConkey's Agar growing Salmonella. Note colorless growth due to the bacteria NOT being a fermenter.
The SPO website is best viewed in Microsoft Explorer, Google Chrome or Apple Safari.
PAGE 2 < Back to Page 1
You have free access to a large collection of materials used in a college-level introductory microbiology course. The Virtual Microbiology Classroom provides a wide range of free educational resources including PowerPoint Lectures, Study Guides, Review Questions and Practice Test Questions.
SCIENCE VIDEOS
Didn't find what you need?
Search SPO for a Photo
End of Article < Back to Page 1
For those in need of high-resolution images, we will soon be offering hi-res files of many photos in the Science Image Library. Follow us on Facebook to get updates on new SPO features and products. If you need a high resolution photo now, please contact us.
 | ||||||
SPO is a FREE science education website. Donations are key in helping us provide this resource with fewer ads.
Please help!
(This donation link uses PayPal on a secure connection.)